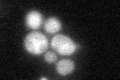
YIL083C
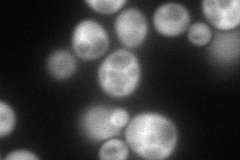
YIL083C
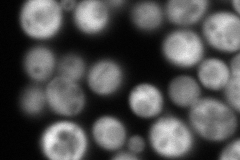
YIL083C
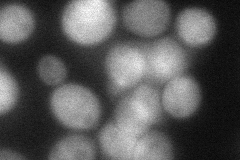
YIL083C
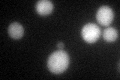
YIL083C
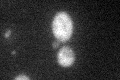
YIL083C
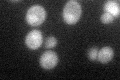
YIL083C

View description
Probable phosphopantothenoylcysteine synthetase (PPCS), which catalyzes the second step of coenzyme A biosynthesis from pantothenate; null mutant lethality is complemented by E. coli coaBC (encoding a bifunctional enzyme with PPCS activity)
Localization:
Intensity:
Fold change:
Significance:
-
C’ GFP library in SD
cytosol41.98 -
N' NOP1pr-GFP in SD
cytosol165.928 -
N' TEF2pr-mCherry in SD
cytosol238.074 -
N' NATIVEpr-GFP in SD

cytosol38.8116 -
N' TEF2pr-VC and Cyto-VN in SD
cytosol68.8096 -
C’ GFP library in SD+DTT
cytosol34.320.81No -
C’ GFP library in SD+H2O2
cytosol41.981No -
C’ GFP library in Starvation Media
cytosol53.891.28No -
C’ GFP library on the background of Pup2-DaMP

cytosol -
C’ GFP library on the background of CCT mutant

cytosol42.40491.00998No
